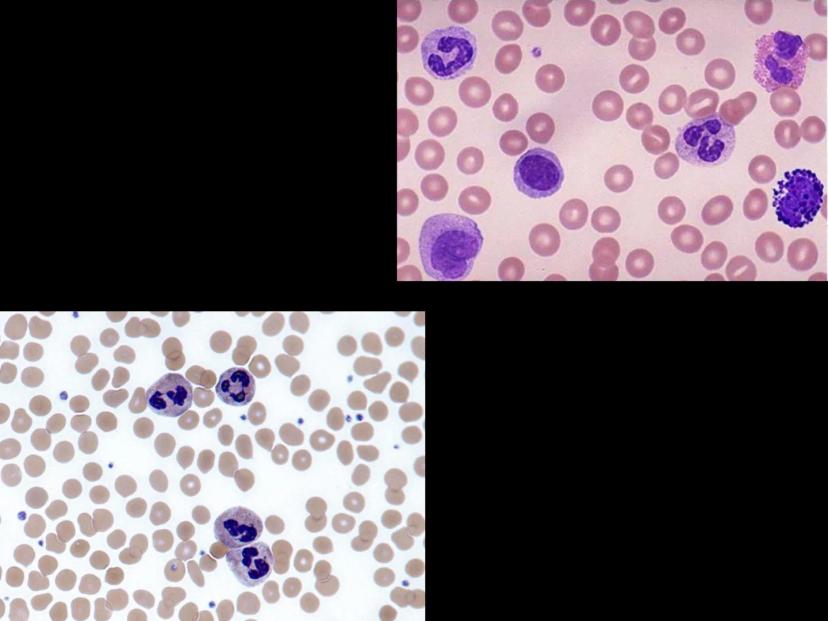
Page 25
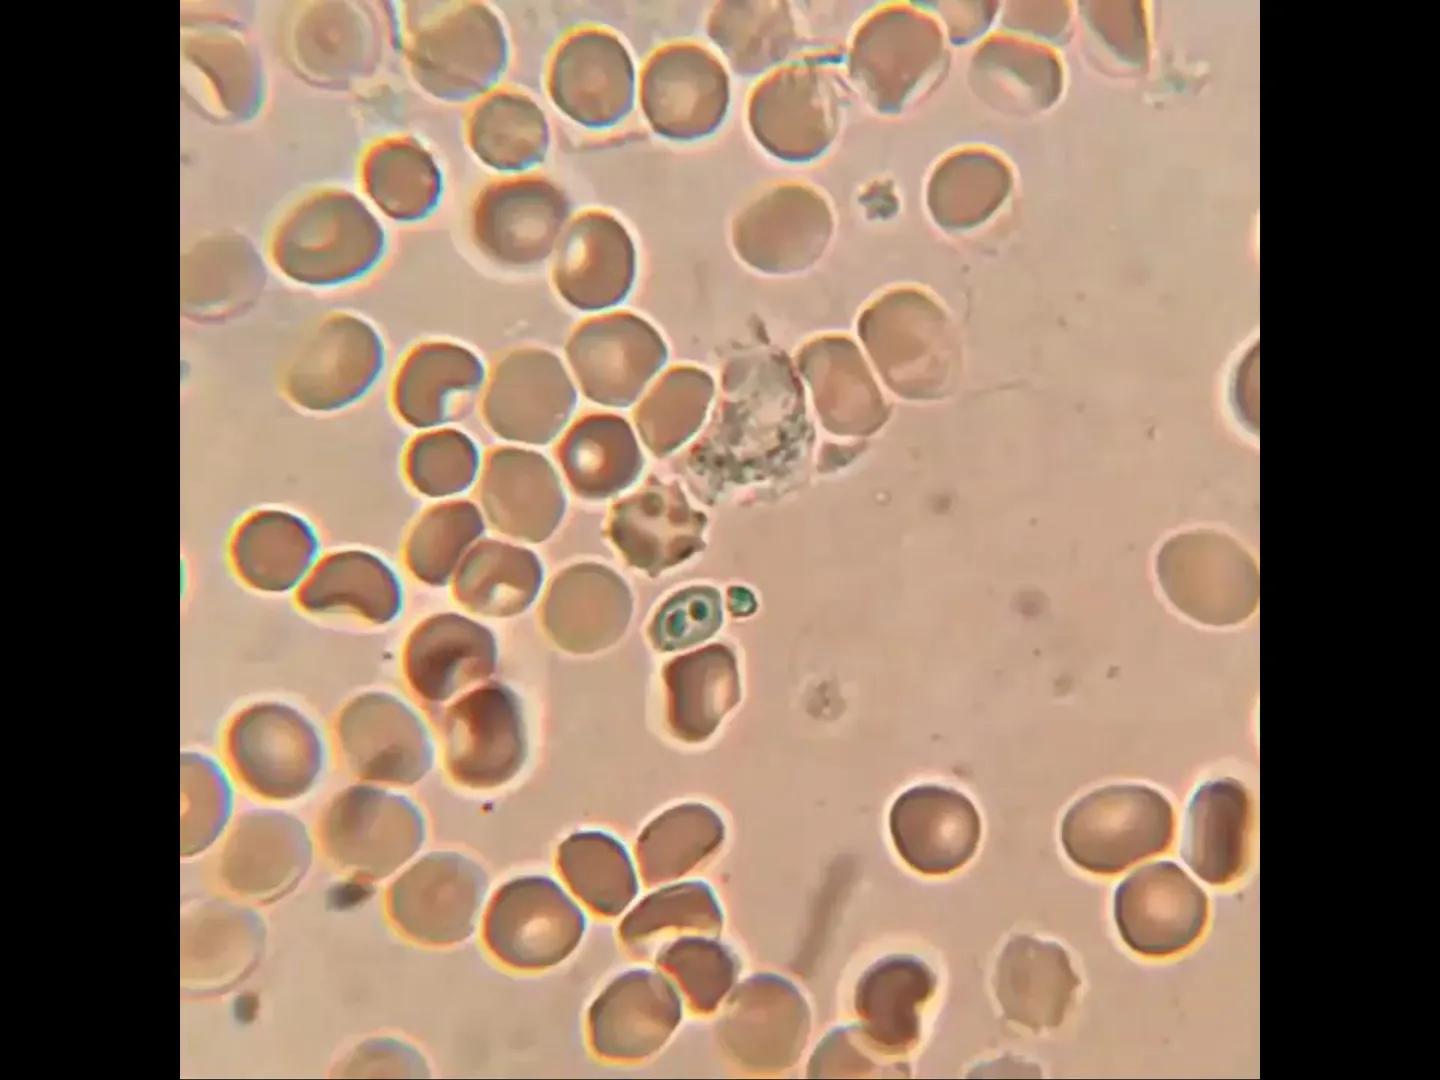
# INMUNOLOGÍA # Inmunidad
La palabra inmunidad significa protección contra la enfermedad y, más en concreto, contra una enfermedad infeccio
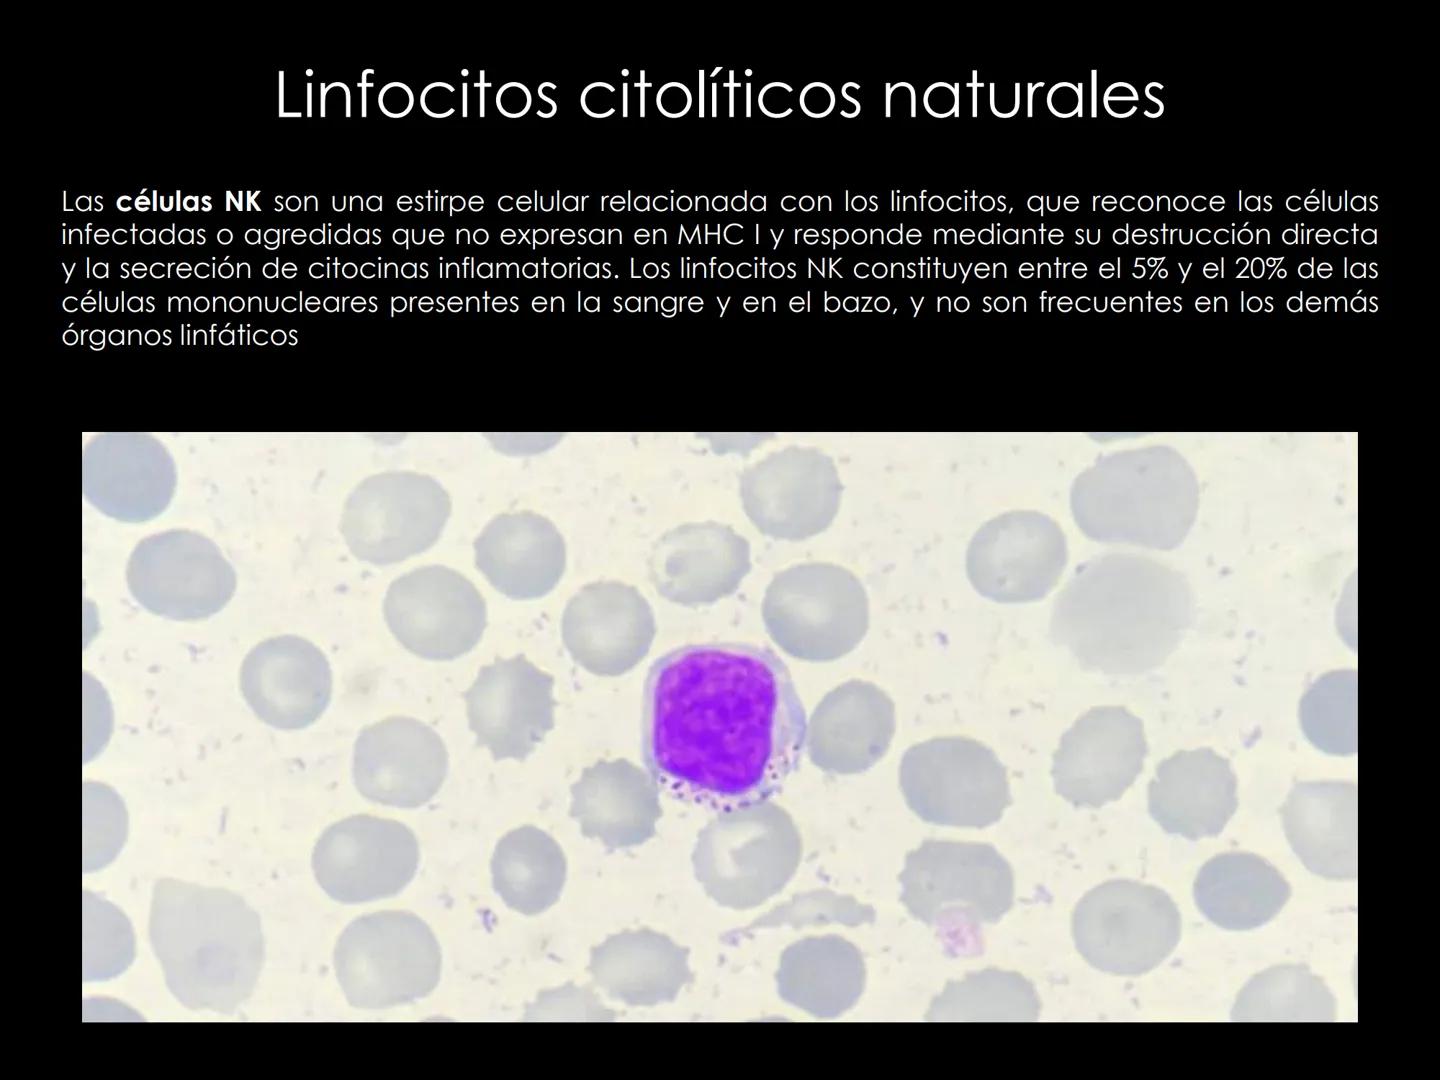
# INMUNOLOGÍA # Inmunidad
La palabra inmunidad significa protección contra la enfermedad y, más en concreto, contra una enfermedad infeccio
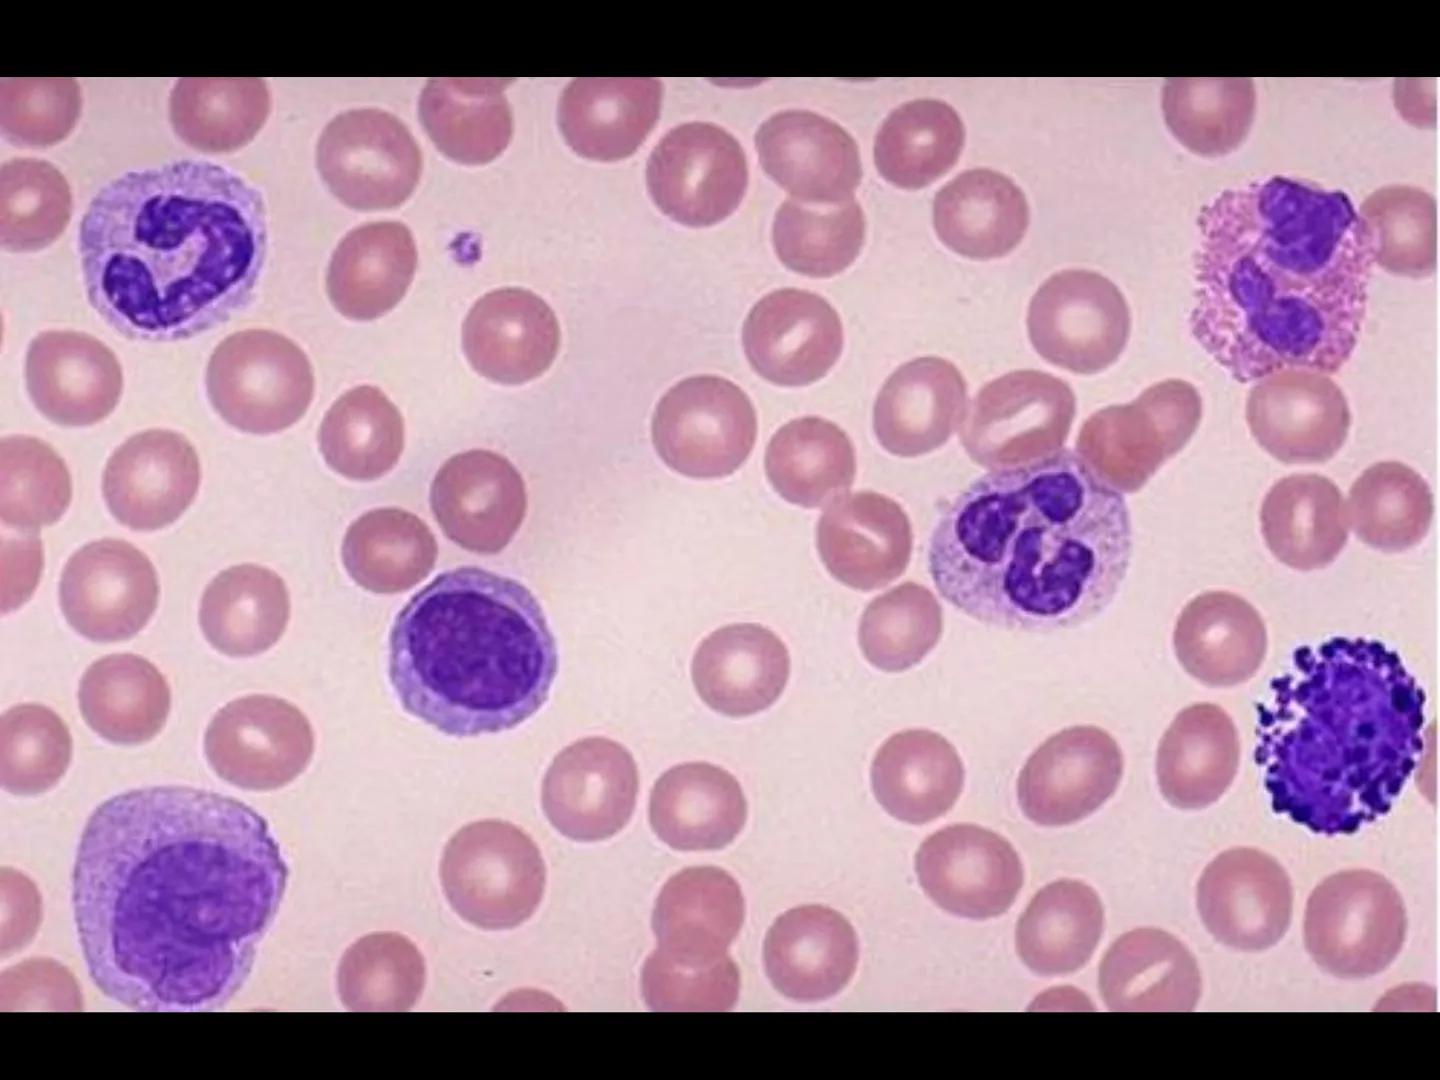
# INMUNOLOGÍA # Inmunidad
La palabra inmunidad significa protección contra la enfermedad y, más en concreto, contra una enfermedad infeccio

La inmunología es tu sistema de defensa personal contra enfermedades... Mostrar más
Inscríbete para ver los apuntes¡Es gratis!
Acceso a todos los documentos
Mejora tus notas
Únete a millones de estudiantes
Knowunity AI
Asignaturas
Triangle Congruence and Similarity Theorems
Triangle Properties and Classification
Linear Equations and Graphs
Geometric Angle Relationships
Trigonometric Functions and Identities
Equation Solving Techniques
Circle Geometry Fundamentals
Division Operations and Methods
Basic Differentiation Rules
Exponent and Logarithm Properties
Mostrar todos los temas
Human Organ Systems
Reproductive Cell Cycles
Biological Sciences Subdisciplines
Cellular Energy Metabolism
Autotrophic Energy Processes
Inheritance Patterns and Principles
Biomolecular Structure and Organization
Cell Cycle and Division Mechanics
Cellular Organization and Development
Biological Structural Organization
Mostrar todos los temas
Chemical Sciences and Applications
Atomic Structure and Composition
Molecular Electron Structure Representation
Atomic Electron Behavior
Matter Properties and Water
Mole Concept and Calculations
Gas Laws and Behavior
Periodic Table Organization
Chemical Thermodynamics Fundamentals
Chemical Bond Types and Properties
Mostrar todos los temas
European Renaissance and Enlightenment
European Cultural Movements 800-1920
American Revolution Era 1763-1797
American Civil War 1861-1865
Global Imperial Systems
Mongol and Chinese Dynasties
U.S. Presidents and World Leaders
Historical Sources and Documentation
World Wars Era and Impact
World Religious Systems
Mostrar todos los temas
Classic and Contemporary Novels
Literary Character Analysis
Rhetorical Theory and Practice
Classic Literary Narratives
Reading Analysis and Interpretation
Narrative Structure and Techniques
English Language Components
Influential English-Language Authors
Basic Sentence Structure
Narrative Voice and Perspective
Mostrar todos los temas
123
•
Actualizado Apr 6, 2026
•
Oniewe132
@oniewe132
La inmunología es tu sistema de defensa personal contra enfermedades... Mostrar más

La inmunología estudia cómo tu cuerpo se protege contra las enfermedades. Es como tener un sistema de seguridad súper avanzado que nunca descansa.
El sistema inmunitario es tu equipo de defensa personal, compuesto por células especializadas y moléculas que patrullan constantemente tu organismo. Cuando detectan algo extraño o peligroso, lanzan una respuesta inmunitaria coordinada para eliminarlo.
Tu cuerpo maneja dos tipos principales de inmunidad: la innata (que naces con ella, como tu primera línea de defensa) y la adquirida (que desarrollas a lo largo de tu vida cuando te expones a diferentes patógenos).
💡 Dato curioso: Tu sistema inmunitario tiene mejor memoria que tú - puede recordar patógenos que enfrentó hace años y reaccionar más rápido la próxima vez.

Los antígenos son básicamente cualquier sustancia extraña que puede provocar una respuesta de tu sistema inmunitario. Piensa en ellos como las "tarjetas de identificación" que llevan los invasores.
Cada antígeno tiene zonas específicas llamadas epítopos o determinantes antigénicos, que son como códigos de barras únicos. Tus anticuerpos leen estos códigos para identificar exactamente qué tipo de invasor están enfrentando.
La inmunogenicidad es la capacidad de un antígeno para despertar a tu sistema inmunitario, mientras que la antigenicidad es su habilidad para interactuar con los anticuerpos o células T que ya tienes.
💡 Tip de estudio: Imagina los epítopos como las llaves únicas de cada invasor, y los anticuerpos como las cerraduras específicas que solo abren con esa llave.

No todos los antígenos son iguales - algunos son más peligrosos y fáciles de detectar que otros. Las proteínas son los antígenos más poderosos porque tienen estructuras complejas con múltiples epítopos, como invasores con muchas señales de alarma.
Los carbohidratos los encuentras en las paredes de bacterias y en los grupos sanguíneos humanos (como el sistema ABO que determina tu tipo de sangre). Los lípidos normalmente son antígenos débiles porque no se disuelven bien en agua.
Los ácidos nucleicos (ADN y ARN) generalmente necesitan ayuda de proteínas para activar tu sistema inmunitario. Sin embargo, en enfermedades autoinmunes, tu cuerpo puede crear anticuerpos contra tu propio ADN.
💡 Conexión real: Cuando te hacen análisis de sangre para determinar tu tipo, están identificando antígenos de carbohidratos en tus glóbulos rojos.

El MHC es como el sistema de identificación nacional de tus células - les dice a tu sistema inmunitario "soy parte del equipo, no me ataques". Este complejo tiene tres clases principales de genes que cumplen funciones específicas.
Los genes Clase I producen antígenos HLA-I que están en casi todas tus células nucleadas (excepto neuronas y glóbulos rojos). Estos le dicen a las células NK "todo está bien aquí, no me destruyas".
Los genes Clase II codifican HLA-II, que normalmente solo aparecen en células especializadas como linfocitos B, macrófagos y células dendríticas. Los genes Clase III producen componentes del complemento y otras moléculas importantes.
💡 Dato importante: Los trasplantes de órganos fallan cuando los MHC del donante y receptor no son compatibles - es como intentar usar la identificación de otra persona.

El sistema de complemento es como tener artillería pesada en tu sistema inmunitario. Son proteínas del hígado que se activan en cascada, como fichas de dominó cayendo una tras otra para crear una respuesta masiva.
Este sistema tiene tres formas principales de eliminar patógenos. Primero, las perforinas literalmente perforan las membranas de los invasores como balas que atraviesan un globo.
Segundo, la opsonización marca a los patógenos como objetivos prioritarios para que los fagocitos los encuentren y devoren más fácilmente. Tercero, las anafilotoxinas estimulan la inflamación activando mastocitos y basófilos.
💡 Analogía útil: El complemento funciona como un sistema de alarma que no solo detecta intrusos, sino que también los marca, los ataca directamente y llama refuerzos.

Las citocinas son las mensajeras químicas que permiten a tus células comunicarse entre sí durante una respuesta inmunitaria. Son como WhatsApp para células - transmiten información vital sobre lo que está pasando.
Estas proteínas solubles se producen temporalmente cuando hay un estímulo específico. Participan en prácticamente todo: proliferación celular, diferenciación, actividad antimicrobiana, inflamación y respuestas inmunitarias.
Las principales familias incluyen factores de necrosis tumoral (TNF), interferones (IFN), interleucinas (IL) y quimiocinas. Cada tipo tiene funciones específicas pero trabajan coordinadamente.
💡 Conexión práctica: Cuando tienes fiebre durante una infección, son las citocinas inflamatorias las que le dicen a tu cerebro que suba la temperatura corporal.

Las citocinas se organizan en equipos especializados según su función. Las inflamatorias son como los primeros respondientes que activan la respuesta de emergencia cuando hay daño o infección.
Las hematopoyéticas controlan la producción y maduración de todas tus células sanguíneas. Las antitumorales (TNF, IFN) son tus cazadores de células cancerosas, induciendo su muerte programada.
Las quimiocinas funcionan como GPS químico, guiando a los fagocitos hacia donde se necesitan. Las supresoras actúan como frenos, evitando que ciertas células crezcan descontroladamente.
💡 Punto clave: Un desbalance en las citocinas puede causar enfermedades autoinmunes o inmunodeficiencias - por eso es crucial que trabajen en armonía.

La apoptosis o muerte celular programada es como el reciclaje natural de tu cuerpo. A diferencia de la muerte accidental por daño, la apoptosis es un proceso ordenado y limpio que no causa inflamación.
Este mecanismo ocurre normalmente cuando una célula completa su ciclo de vida o cuando necesita ser eliminada por seguridad. Es fundamental para el desarrollo normal y el mantenimiento de tejidos sanos.
Lo genial de la apoptosis es que no libera enzimas tóxicas que dañen tejidos vecinos. Es como desmantelar cuidadosamente un edificio viejo en lugar de volarlo con dinamita.
💡 Importancia clínica: Muchas terapias contra el cáncer funcionan induciendo apoptosis en células tumorales, aprovechando este mecanismo natural de limpieza celular.



































































Nuestro compañero de IA está específicamente adaptado a las necesidades de los estudiantes. Basándonos en los millones de contenidos que tenemos en la plataforma, podemos dar a los estudiantes respuestas realmente significativas y relevantes. Pero no se trata solo de respuestas, el compañero también guía a los estudiantes a través de sus retos de aprendizaje diarios, con planes de aprendizaje personalizados, cuestionarios o contenidos en el chat y una personalización del 100% basada en las habilidades y el desarrollo de los estudiantes.
Puedes descargar la app en Google Play Store y Apple App Store.
¡Sí lo es! Tienes acceso totalmente gratuito a todo el contenido de la app, puedes chatear con otros alumnos y recibir ayuda inmeditamente. Puedes ganar dinero utilizando la aplicación, que te permitirá acceder a determinadas funciones.
App Store
Google Play
La app es muy fácil de usar y está muy bien diseñada. Hasta ahora he encontrado todo lo que estaba buscando y he podido aprender mucho de las presentaciones. Definitivamente utilizaré la aplicación para un examen de clase. Y, por supuesto, también me sirve mucho de inspiración.
Pablo
usuario de iOS
Esta app es realmente genial. Hay tantos apuntes de clase y ayuda [...]. Tengo problemas con matemáticas, por ejemplo, y la aplicación tiene muchas opciones de ayuda. Gracias a Knowunity, he mejorado en mates. Se la recomiendo a todo el mundo.
Elena
usuaria de Android
Vaya, estoy realmente sorprendida. Acabo de probar la app porque la he visto anunciada muchas veces y me he quedado absolutamente alucinada. Esta app es LA AYUDA que quieres para el insti y, sobre todo, ofrece muchísimas cosas, como ejercicios y hojas informativas, que a mí personalmente me han sido MUY útiles.
Ana
usuaria de iOS
Solía tener dificultades para completar mis tareas a tiempo hasta que descubrí Knowunity, que no solo facilita subir mi propio contenido sino que también proporciona excelentes resúmenes que hacen mi trabajo más rápido y eficiente.
Thomas R
usuario de iOS
Siempre era un desafío encontrar toda la información importante para mis tareas – desde que comencé a usar Knowunity, puedo simplemente subir mi contenido y beneficiarme de los resúmenes de otros, lo que me ayuda mucho con la organización.
Lisa M
usuario de Android
A menudo sentía que no tenía suficiente visión general al estudiar, pero desde que comencé a usar Knowunity, eso ya no es un problema – subo mi contenido y siempre encuentro resúmenes útiles en la plataforma, lo que hace mi aprendizaje mucho más fácil.
David K
usuario de iOS
¡La app es buenísima! Sólo tengo que introducir el tema en la barra de búsqueda y recibo la respuesta muy rápido. No tengo que ver 10 vídeos de YouTube para entender algo, así que me ahorro tiempo. ¡Muy recomendable!
Sara
usuaria de Android
En el instituto era muy malo en matemáticas, pero gracias a la app, ahora saco mejores notas. Os agradezco mucho que hayáis creado la aplicación.
Roberto
usuario de Android
Solía ser muy difícil reunir toda la información para mis presentaciones. Pero desde que comencé a usar Knowunity, solo subo mis notas y encuentro increíbles resúmenes de otros – ¡hace mi estudio mucho más eficiente!
Julia S
usuario de Android
Siempre estaba estresado con todo el material de estudio, pero desde que comencé a usar Knowunity, subo mis cosas y reviso los geniales resúmenes de otros – realmente me ayuda a manejar todo mejor y es mucho menos estresante.
Marco B
usuario de iOS
LOS QUIZZES Y FLASHCARDS SON SÚPER ÚTILES Y AMO Knowunity AI. TAMBIÉN ES LITERALMENTE COMO CHATGPT PERO MÁS INTELIGENTE!! ME AYUDÓ CON MIS PROBLEMAS DE RÍMEL TAMBIÉN!! Y CON MIS MATERIAS REALES OBVIO! 😍😁😲🤑💗✨🎀😮
Sarah L
usuario de Android
Antes pasaba horas buscando en Google materiales escolares, pero ahora solo subo mis cosas a Knowunity y reviso los útiles resúmenes de otros – me siento mucho más seguro cuando me preparo para los exámenes.
Paul T
usuario de iOS
La app es muy fácil de usar y está muy bien diseñada. Hasta ahora he encontrado todo lo que estaba buscando y he podido aprender mucho de las presentaciones. Definitivamente utilizaré la aplicación para un examen de clase. Y, por supuesto, también me sirve mucho de inspiración.
Pablo
usuario de iOS
Esta app es realmente genial. Hay tantos apuntes de clase y ayuda [...]. Tengo problemas con matemáticas, por ejemplo, y la aplicación tiene muchas opciones de ayuda. Gracias a Knowunity, he mejorado en mates. Se la recomiendo a todo el mundo.
Elena
usuaria de Android
Vaya, estoy realmente sorprendida. Acabo de probar la app porque la he visto anunciada muchas veces y me he quedado absolutamente alucinada. Esta app es LA AYUDA que quieres para el insti y, sobre todo, ofrece muchísimas cosas, como ejercicios y hojas informativas, que a mí personalmente me han sido MUY útiles.
Ana
usuaria de iOS
Solía tener dificultades para completar mis tareas a tiempo hasta que descubrí Knowunity, que no solo facilita subir mi propio contenido sino que también proporciona excelentes resúmenes que hacen mi trabajo más rápido y eficiente.
Thomas R
usuario de iOS
Siempre era un desafío encontrar toda la información importante para mis tareas – desde que comencé a usar Knowunity, puedo simplemente subir mi contenido y beneficiarme de los resúmenes de otros, lo que me ayuda mucho con la organización.
Lisa M
usuario de Android
A menudo sentía que no tenía suficiente visión general al estudiar, pero desde que comencé a usar Knowunity, eso ya no es un problema – subo mi contenido y siempre encuentro resúmenes útiles en la plataforma, lo que hace mi aprendizaje mucho más fácil.
David K
usuario de iOS
¡La app es buenísima! Sólo tengo que introducir el tema en la barra de búsqueda y recibo la respuesta muy rápido. No tengo que ver 10 vídeos de YouTube para entender algo, así que me ahorro tiempo. ¡Muy recomendable!
Sara
usuaria de Android
En el instituto era muy malo en matemáticas, pero gracias a la app, ahora saco mejores notas. Os agradezco mucho que hayáis creado la aplicación.
Roberto
usuario de Android
Solía ser muy difícil reunir toda la información para mis presentaciones. Pero desde que comencé a usar Knowunity, solo subo mis notas y encuentro increíbles resúmenes de otros – ¡hace mi estudio mucho más eficiente!
Julia S
usuario de Android
Siempre estaba estresado con todo el material de estudio, pero desde que comencé a usar Knowunity, subo mis cosas y reviso los geniales resúmenes de otros – realmente me ayuda a manejar todo mejor y es mucho menos estresante.
Marco B
usuario de iOS
LOS QUIZZES Y FLASHCARDS SON SÚPER ÚTILES Y AMO Knowunity AI. TAMBIÉN ES LITERALMENTE COMO CHATGPT PERO MÁS INTELIGENTE!! ME AYUDÓ CON MIS PROBLEMAS DE RÍMEL TAMBIÉN!! Y CON MIS MATERIAS REALES OBVIO! 😍😁😲🤑💗✨🎀😮
Sarah L
usuario de Android
Antes pasaba horas buscando en Google materiales escolares, pero ahora solo subo mis cosas a Knowunity y reviso los útiles resúmenes de otros – me siento mucho más seguro cuando me preparo para los exámenes.
Paul T
usuario de iOS
Oniewe132
@oniewe132
La inmunología es tu sistema de defensa personal contra enfermedades e infecciones. Tu cuerpo tiene un ejército increíble de células y moléculas que trabajan 24/7 para protegerte de virus, bacterias y otros invasores.

Acceso a todos los documentos
Mejora tus notas
Únete a millones de estudiantes
La inmunología estudia cómo tu cuerpo se protege contra las enfermedades. Es como tener un sistema de seguridad súper avanzado que nunca descansa.
El sistema inmunitario es tu equipo de defensa personal, compuesto por células especializadas y moléculas que patrullan constantemente tu organismo. Cuando detectan algo extraño o peligroso, lanzan una respuesta inmunitaria coordinada para eliminarlo.
Tu cuerpo maneja dos tipos principales de inmunidad: la innata (que naces con ella, como tu primera línea de defensa) y la adquirida (que desarrollas a lo largo de tu vida cuando te expones a diferentes patógenos).
💡 Dato curioso: Tu sistema inmunitario tiene mejor memoria que tú - puede recordar patógenos que enfrentó hace años y reaccionar más rápido la próxima vez.

Acceso a todos los documentos
Mejora tus notas
Únete a millones de estudiantes
Los antígenos son básicamente cualquier sustancia extraña que puede provocar una respuesta de tu sistema inmunitario. Piensa en ellos como las "tarjetas de identificación" que llevan los invasores.
Cada antígeno tiene zonas específicas llamadas epítopos o determinantes antigénicos, que son como códigos de barras únicos. Tus anticuerpos leen estos códigos para identificar exactamente qué tipo de invasor están enfrentando.
La inmunogenicidad es la capacidad de un antígeno para despertar a tu sistema inmunitario, mientras que la antigenicidad es su habilidad para interactuar con los anticuerpos o células T que ya tienes.
💡 Tip de estudio: Imagina los epítopos como las llaves únicas de cada invasor, y los anticuerpos como las cerraduras específicas que solo abren con esa llave.

Acceso a todos los documentos
Mejora tus notas
Únete a millones de estudiantes
No todos los antígenos son iguales - algunos son más peligrosos y fáciles de detectar que otros. Las proteínas son los antígenos más poderosos porque tienen estructuras complejas con múltiples epítopos, como invasores con muchas señales de alarma.
Los carbohidratos los encuentras en las paredes de bacterias y en los grupos sanguíneos humanos (como el sistema ABO que determina tu tipo de sangre). Los lípidos normalmente son antígenos débiles porque no se disuelven bien en agua.
Los ácidos nucleicos (ADN y ARN) generalmente necesitan ayuda de proteínas para activar tu sistema inmunitario. Sin embargo, en enfermedades autoinmunes, tu cuerpo puede crear anticuerpos contra tu propio ADN.
💡 Conexión real: Cuando te hacen análisis de sangre para determinar tu tipo, están identificando antígenos de carbohidratos en tus glóbulos rojos.

Acceso a todos los documentos
Mejora tus notas
Únete a millones de estudiantes
El MHC es como el sistema de identificación nacional de tus células - les dice a tu sistema inmunitario "soy parte del equipo, no me ataques". Este complejo tiene tres clases principales de genes que cumplen funciones específicas.
Los genes Clase I producen antígenos HLA-I que están en casi todas tus células nucleadas (excepto neuronas y glóbulos rojos). Estos le dicen a las células NK "todo está bien aquí, no me destruyas".
Los genes Clase II codifican HLA-II, que normalmente solo aparecen en células especializadas como linfocitos B, macrófagos y células dendríticas. Los genes Clase III producen componentes del complemento y otras moléculas importantes.
💡 Dato importante: Los trasplantes de órganos fallan cuando los MHC del donante y receptor no son compatibles - es como intentar usar la identificación de otra persona.

Acceso a todos los documentos
Mejora tus notas
Únete a millones de estudiantes
El sistema de complemento es como tener artillería pesada en tu sistema inmunitario. Son proteínas del hígado que se activan en cascada, como fichas de dominó cayendo una tras otra para crear una respuesta masiva.
Este sistema tiene tres formas principales de eliminar patógenos. Primero, las perforinas literalmente perforan las membranas de los invasores como balas que atraviesan un globo.
Segundo, la opsonización marca a los patógenos como objetivos prioritarios para que los fagocitos los encuentren y devoren más fácilmente. Tercero, las anafilotoxinas estimulan la inflamación activando mastocitos y basófilos.
💡 Analogía útil: El complemento funciona como un sistema de alarma que no solo detecta intrusos, sino que también los marca, los ataca directamente y llama refuerzos.

Acceso a todos los documentos
Mejora tus notas
Únete a millones de estudiantes
Las citocinas son las mensajeras químicas que permiten a tus células comunicarse entre sí durante una respuesta inmunitaria. Son como WhatsApp para células - transmiten información vital sobre lo que está pasando.
Estas proteínas solubles se producen temporalmente cuando hay un estímulo específico. Participan en prácticamente todo: proliferación celular, diferenciación, actividad antimicrobiana, inflamación y respuestas inmunitarias.
Las principales familias incluyen factores de necrosis tumoral (TNF), interferones (IFN), interleucinas (IL) y quimiocinas. Cada tipo tiene funciones específicas pero trabajan coordinadamente.
💡 Conexión práctica: Cuando tienes fiebre durante una infección, son las citocinas inflamatorias las que le dicen a tu cerebro que suba la temperatura corporal.

Acceso a todos los documentos
Mejora tus notas
Únete a millones de estudiantes
Las citocinas se organizan en equipos especializados según su función. Las inflamatorias son como los primeros respondientes que activan la respuesta de emergencia cuando hay daño o infección.
Las hematopoyéticas controlan la producción y maduración de todas tus células sanguíneas. Las antitumorales (TNF, IFN) son tus cazadores de células cancerosas, induciendo su muerte programada.
Las quimiocinas funcionan como GPS químico, guiando a los fagocitos hacia donde se necesitan. Las supresoras actúan como frenos, evitando que ciertas células crezcan descontroladamente.
💡 Punto clave: Un desbalance en las citocinas puede causar enfermedades autoinmunes o inmunodeficiencias - por eso es crucial que trabajen en armonía.

Acceso a todos los documentos
Mejora tus notas
Únete a millones de estudiantes
La apoptosis o muerte celular programada es como el reciclaje natural de tu cuerpo. A diferencia de la muerte accidental por daño, la apoptosis es un proceso ordenado y limpio que no causa inflamación.
Este mecanismo ocurre normalmente cuando una célula completa su ciclo de vida o cuando necesita ser eliminada por seguridad. Es fundamental para el desarrollo normal y el mantenimiento de tejidos sanos.
Lo genial de la apoptosis es que no libera enzimas tóxicas que dañen tejidos vecinos. Es como desmantelar cuidadosamente un edificio viejo en lugar de volarlo con dinamita.
💡 Importancia clínica: Muchas terapias contra el cáncer funcionan induciendo apoptosis en células tumorales, aprovechando este mecanismo natural de limpieza celular.

Acceso a todos los documentos
Mejora tus notas
Únete a millones de estudiantes

Acceso a todos los documentos
Mejora tus notas
Únete a millones de estudiantes

Acceso a todos los documentos
Mejora tus notas
Únete a millones de estudiantes

Acceso a todos los documentos
Mejora tus notas
Únete a millones de estudiantes

Acceso a todos los documentos
Mejora tus notas
Únete a millones de estudiantes

Acceso a todos los documentos
Mejora tus notas
Únete a millones de estudiantes

Acceso a todos los documentos
Mejora tus notas
Únete a millones de estudiantes

Acceso a todos los documentos
Mejora tus notas
Únete a millones de estudiantes

Acceso a todos los documentos
Mejora tus notas
Únete a millones de estudiantes

Acceso a todos los documentos
Mejora tus notas
Únete a millones de estudiantes

Acceso a todos los documentos
Mejora tus notas
Únete a millones de estudiantes

Acceso a todos los documentos
Mejora tus notas
Únete a millones de estudiantes

Acceso a todos los documentos
Mejora tus notas
Únete a millones de estudiantes

Acceso a todos los documentos
Mejora tus notas
Únete a millones de estudiantes

Acceso a todos los documentos
Mejora tus notas
Únete a millones de estudiantes

Acceso a todos los documentos
Mejora tus notas
Únete a millones de estudiantes

Acceso a todos los documentos
Mejora tus notas
Únete a millones de estudiantes

Acceso a todos los documentos
Mejora tus notas
Únete a millones de estudiantes

Acceso a todos los documentos
Mejora tus notas
Únete a millones de estudiantes

Acceso a todos los documentos
Mejora tus notas
Únete a millones de estudiantes

Acceso a todos los documentos
Mejora tus notas
Únete a millones de estudiantes

Acceso a todos los documentos
Mejora tus notas
Únete a millones de estudiantes

Acceso a todos los documentos
Mejora tus notas
Únete a millones de estudiantes

Acceso a todos los documentos
Mejora tus notas
Únete a millones de estudiantes

Acceso a todos los documentos
Mejora tus notas
Únete a millones de estudiantes

Acceso a todos los documentos
Mejora tus notas
Únete a millones de estudiantes
Acceso a todos los documentos
Mejora tus notas
Únete a millones de estudiantes

Acceso a todos los documentos
Mejora tus notas
Únete a millones de estudiantes

Acceso a todos los documentos
Mejora tus notas
Únete a millones de estudiantes

Acceso a todos los documentos
Mejora tus notas
Únete a millones de estudiantes

Acceso a todos los documentos
Mejora tus notas
Únete a millones de estudiantes
Acceso a todos los documentos
Mejora tus notas
Únete a millones de estudiantes

Acceso a todos los documentos
Mejora tus notas
Únete a millones de estudiantes

Acceso a todos los documentos
Mejora tus notas
Únete a millones de estudiantes
Acceso a todos los documentos
Mejora tus notas
Únete a millones de estudiantes

Acceso a todos los documentos
Mejora tus notas
Únete a millones de estudiantes

Acceso a todos los documentos
Mejora tus notas
Únete a millones de estudiantes

Acceso a todos los documentos
Mejora tus notas
Únete a millones de estudiantes

Acceso a todos los documentos
Mejora tus notas
Únete a millones de estudiantes

Acceso a todos los documentos
Mejora tus notas
Únete a millones de estudiantes

Acceso a todos los documentos
Mejora tus notas
Únete a millones de estudiantes

Acceso a todos los documentos
Mejora tus notas
Únete a millones de estudiantes

Acceso a todos los documentos
Mejora tus notas
Únete a millones de estudiantes

Acceso a todos los documentos
Mejora tus notas
Únete a millones de estudiantes

Acceso a todos los documentos
Mejora tus notas
Únete a millones de estudiantes

Acceso a todos los documentos
Mejora tus notas
Únete a millones de estudiantes

Acceso a todos los documentos
Mejora tus notas
Únete a millones de estudiantes

Acceso a todos los documentos
Mejora tus notas
Únete a millones de estudiantes

Acceso a todos los documentos
Mejora tus notas
Únete a millones de estudiantes

Acceso a todos los documentos
Mejora tus notas
Únete a millones de estudiantes

Acceso a todos los documentos
Mejora tus notas
Únete a millones de estudiantes

Acceso a todos los documentos
Mejora tus notas
Únete a millones de estudiantes

Acceso a todos los documentos
Mejora tus notas
Únete a millones de estudiantes

Acceso a todos los documentos
Mejora tus notas
Únete a millones de estudiantes

Acceso a todos los documentos
Mejora tus notas
Únete a millones de estudiantes

Acceso a todos los documentos
Mejora tus notas
Únete a millones de estudiantes

Acceso a todos los documentos
Mejora tus notas
Únete a millones de estudiantes

Acceso a todos los documentos
Mejora tus notas
Únete a millones de estudiantes

Acceso a todos los documentos
Mejora tus notas
Únete a millones de estudiantes

Acceso a todos los documentos
Mejora tus notas
Únete a millones de estudiantes

Acceso a todos los documentos
Mejora tus notas
Únete a millones de estudiantes

Acceso a todos los documentos
Mejora tus notas
Únete a millones de estudiantes

Acceso a todos los documentos
Mejora tus notas
Únete a millones de estudiantes

Acceso a todos los documentos
Mejora tus notas
Únete a millones de estudiantes

Acceso a todos los documentos
Mejora tus notas
Únete a millones de estudiantes

Acceso a todos los documentos
Mejora tus notas
Únete a millones de estudiantes

Acceso a todos los documentos
Mejora tus notas
Únete a millones de estudiantes
Nuestro compañero de IA está específicamente adaptado a las necesidades de los estudiantes. Basándonos en los millones de contenidos que tenemos en la plataforma, podemos dar a los estudiantes respuestas realmente significativas y relevantes. Pero no se trata solo de respuestas, el compañero también guía a los estudiantes a través de sus retos de aprendizaje diarios, con planes de aprendizaje personalizados, cuestionarios o contenidos en el chat y una personalización del 100% basada en las habilidades y el desarrollo de los estudiantes.
Puedes descargar la app en Google Play Store y Apple App Store.
¡Sí lo es! Tienes acceso totalmente gratuito a todo el contenido de la app, puedes chatear con otros alumnos y recibir ayuda inmeditamente. Puedes ganar dinero utilizando la aplicación, que te permitirá acceder a determinadas funciones.
4
Herramientas Inteligentes NUEVO
Convierte estos apuntes en: ✓ 50+ Preguntas de Práctica ✓ Tarjetas de Estudio Interactivas ✓ Examen Completo de Práctica ✓ Esquemas de Ensayo
App Store
Google Play
La app es muy fácil de usar y está muy bien diseñada. Hasta ahora he encontrado todo lo que estaba buscando y he podido aprender mucho de las presentaciones. Definitivamente utilizaré la aplicación para un examen de clase. Y, por supuesto, también me sirve mucho de inspiración.
Pablo
usuario de iOS
Esta app es realmente genial. Hay tantos apuntes de clase y ayuda [...]. Tengo problemas con matemáticas, por ejemplo, y la aplicación tiene muchas opciones de ayuda. Gracias a Knowunity, he mejorado en mates. Se la recomiendo a todo el mundo.
Elena
usuaria de Android
Vaya, estoy realmente sorprendida. Acabo de probar la app porque la he visto anunciada muchas veces y me he quedado absolutamente alucinada. Esta app es LA AYUDA que quieres para el insti y, sobre todo, ofrece muchísimas cosas, como ejercicios y hojas informativas, que a mí personalmente me han sido MUY útiles.
Ana
usuaria de iOS
Solía tener dificultades para completar mis tareas a tiempo hasta que descubrí Knowunity, que no solo facilita subir mi propio contenido sino que también proporciona excelentes resúmenes que hacen mi trabajo más rápido y eficiente.
Thomas R
usuario de iOS
Siempre era un desafío encontrar toda la información importante para mis tareas – desde que comencé a usar Knowunity, puedo simplemente subir mi contenido y beneficiarme de los resúmenes de otros, lo que me ayuda mucho con la organización.
Lisa M
usuario de Android
A menudo sentía que no tenía suficiente visión general al estudiar, pero desde que comencé a usar Knowunity, eso ya no es un problema – subo mi contenido y siempre encuentro resúmenes útiles en la plataforma, lo que hace mi aprendizaje mucho más fácil.
David K
usuario de iOS
¡La app es buenísima! Sólo tengo que introducir el tema en la barra de búsqueda y recibo la respuesta muy rápido. No tengo que ver 10 vídeos de YouTube para entender algo, así que me ahorro tiempo. ¡Muy recomendable!
Sara
usuaria de Android
En el instituto era muy malo en matemáticas, pero gracias a la app, ahora saco mejores notas. Os agradezco mucho que hayáis creado la aplicación.
Roberto
usuario de Android
Solía ser muy difícil reunir toda la información para mis presentaciones. Pero desde que comencé a usar Knowunity, solo subo mis notas y encuentro increíbles resúmenes de otros – ¡hace mi estudio mucho más eficiente!
Julia S
usuario de Android
Siempre estaba estresado con todo el material de estudio, pero desde que comencé a usar Knowunity, subo mis cosas y reviso los geniales resúmenes de otros – realmente me ayuda a manejar todo mejor y es mucho menos estresante.
Marco B
usuario de iOS
LOS QUIZZES Y FLASHCARDS SON SÚPER ÚTILES Y AMO Knowunity AI. TAMBIÉN ES LITERALMENTE COMO CHATGPT PERO MÁS INTELIGENTE!! ME AYUDÓ CON MIS PROBLEMAS DE RÍMEL TAMBIÉN!! Y CON MIS MATERIAS REALES OBVIO! 😍😁😲🤑💗✨🎀😮
Sarah L
usuario de Android
Antes pasaba horas buscando en Google materiales escolares, pero ahora solo subo mis cosas a Knowunity y reviso los útiles resúmenes de otros – me siento mucho más seguro cuando me preparo para los exámenes.
Paul T
usuario de iOS
La app es muy fácil de usar y está muy bien diseñada. Hasta ahora he encontrado todo lo que estaba buscando y he podido aprender mucho de las presentaciones. Definitivamente utilizaré la aplicación para un examen de clase. Y, por supuesto, también me sirve mucho de inspiración.
Pablo
usuario de iOS
Esta app es realmente genial. Hay tantos apuntes de clase y ayuda [...]. Tengo problemas con matemáticas, por ejemplo, y la aplicación tiene muchas opciones de ayuda. Gracias a Knowunity, he mejorado en mates. Se la recomiendo a todo el mundo.
Elena
usuaria de Android
Vaya, estoy realmente sorprendida. Acabo de probar la app porque la he visto anunciada muchas veces y me he quedado absolutamente alucinada. Esta app es LA AYUDA que quieres para el insti y, sobre todo, ofrece muchísimas cosas, como ejercicios y hojas informativas, que a mí personalmente me han sido MUY útiles.
Ana
usuaria de iOS
Solía tener dificultades para completar mis tareas a tiempo hasta que descubrí Knowunity, que no solo facilita subir mi propio contenido sino que también proporciona excelentes resúmenes que hacen mi trabajo más rápido y eficiente.
Thomas R
usuario de iOS
Siempre era un desafío encontrar toda la información importante para mis tareas – desde que comencé a usar Knowunity, puedo simplemente subir mi contenido y beneficiarme de los resúmenes de otros, lo que me ayuda mucho con la organización.
Lisa M
usuario de Android
A menudo sentía que no tenía suficiente visión general al estudiar, pero desde que comencé a usar Knowunity, eso ya no es un problema – subo mi contenido y siempre encuentro resúmenes útiles en la plataforma, lo que hace mi aprendizaje mucho más fácil.
David K
usuario de iOS
¡La app es buenísima! Sólo tengo que introducir el tema en la barra de búsqueda y recibo la respuesta muy rápido. No tengo que ver 10 vídeos de YouTube para entender algo, así que me ahorro tiempo. ¡Muy recomendable!
Sara
usuaria de Android
En el instituto era muy malo en matemáticas, pero gracias a la app, ahora saco mejores notas. Os agradezco mucho que hayáis creado la aplicación.
Roberto
usuario de Android
Solía ser muy difícil reunir toda la información para mis presentaciones. Pero desde que comencé a usar Knowunity, solo subo mis notas y encuentro increíbles resúmenes de otros – ¡hace mi estudio mucho más eficiente!
Julia S
usuario de Android
Siempre estaba estresado con todo el material de estudio, pero desde que comencé a usar Knowunity, subo mis cosas y reviso los geniales resúmenes de otros – realmente me ayuda a manejar todo mejor y es mucho menos estresante.
Marco B
usuario de iOS
LOS QUIZZES Y FLASHCARDS SON SÚPER ÚTILES Y AMO Knowunity AI. TAMBIÉN ES LITERALMENTE COMO CHATGPT PERO MÁS INTELIGENTE!! ME AYUDÓ CON MIS PROBLEMAS DE RÍMEL TAMBIÉN!! Y CON MIS MATERIAS REALES OBVIO! 😍😁😲🤑💗✨🎀😮
Sarah L
usuario de Android
Antes pasaba horas buscando en Google materiales escolares, pero ahora solo subo mis cosas a Knowunity y reviso los útiles resúmenes de otros – me siento mucho más seguro cuando me preparo para los exámenes.
Paul T
usuario de iOS